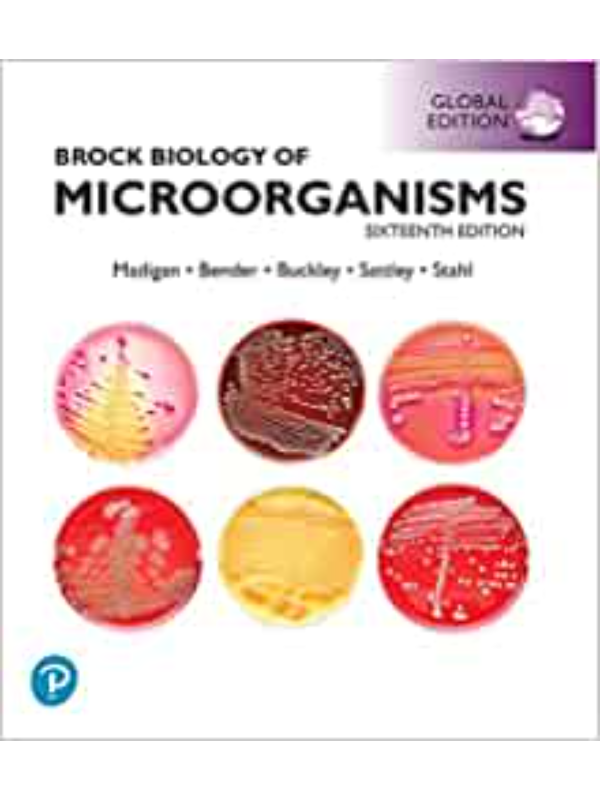
9781292404790 Brock Biology of Microorganisms, Global Edition - Image 1

-
- Uzrast 0 do 3 godine
- Uzrast 3 do 6 godina
- Uzrast 7 do 9 godina
- Uzrast 10 do 12 godina
- Nauka, umetnost, istorija i opšta interesovanja
- Bajke, basne, mitovi i legende
- Lektira, književnost i poezija
- Odrastanje, duh i telo
- Priručnici
- Enciklopedije
- Za čitaoce početnike
- Romani i priče
-
- Edicija Minimiki
- Zec Petar
-
- Radni listovi i dodatni materijali (vrtić)
-
- Tinejdž i YA
- Romani i priče
The Light We Carry : Overcoming in Uncertain Times
3,878.00RSD Originalna cena je bila: 3,878.00RSD.2,714.60RSDTrenutna cena je: 2,714.60RSD.
Mesečeva deca
2,035.00RSD
Brock Biology of Microorganisms, Global Edition
Šifra proizvoda:
9781292404790
Cena:
8,994.00RSD
Na zalihama
Brock Biology of Microorganism
Pročitali ste ovu knjigu? - Napišite svoje mišljenje o Brock Biology of Microorganisms, Global Edition” Odustani od odgovora
Kategorije: Biology, English Books
| Jedinica mere | |
|---|---|
| Godina izdanja | |
| Izdavač | |
| Autor |
Michael Madigan, Jennifer Aiyer, Daniel Buckley , W. Sattley |
| Jezik | |
| Pismo |
9781292404790 1292404790
Za više informacija o proizvodu poslati upit na webshop@datastatus.rs
Od istog autora
Na žalost nemamo više izdanja ovog autora.










Kapitalna izdanja i monografije
Recenzije
Još nema komentara.